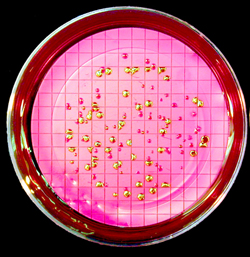

Microbiology

The BIOS Microbiology Research Program includes Virology (Sunter), Fungal Genetics (Calvo-Byrd) and Bacteriology (Zhou, Singh, Swingley and Henson). Microbiology also contributes heavily to the Biomedical Sciences program in addition to serving as a defined focus area. Students with microbiology training are extremely marketable for employment post-graduation and also are well prepared to enter health-related careers, the biotechnology industry or graduate school.
Image courtesy of Dr. Richard Becker.